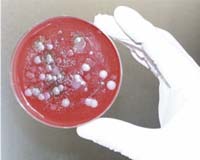

|
Washington (UPI) Sep 11, 2009 Pity the al-Qaida analyst in the 16-agency, 100,000-strong U.S. intelligence community that spends $50 billion a year, much of it to track al-Qaida operatives the world over. President Obama made clear during last year's presidential campaign Afghanistan would be his war if elected. And since being sworn in, true to his word, the Afghan war is now a national security imperative because that's where al-Qaida is. At least that's where Obama thinks it is. But nothing is less certain. On the eighth anniversary of Sept. 11, 2001, al-Qaida is everywhere and nowhere at the same time. The Islamist terrorist organization would not maintain bases in Afghanistan with a war that now extends to every part of the Texas-size country. But al-Qaida does have safe houses and underground shelters in Pakistan's tribal areas on the Afghan border. It also has a worldwide presence on the Internet, and millions of clandestine followers from Mindanao in the Philippines to the Persian Gulf States to Yemen to Somalia to North, West and East Africa, and possibly a few in Latin America. One percent of 1.3 billion Muslims -- or 13 million -- is the estimated number of religious extremists prone to violence to propagate their palpably fraudulent version of the prophet's teachings. The Middle East Media Research Institute, which has ties to Israel's intelligence community, keeps eyes and ears peeled for the slightest al-Qaida vibration in cyberspace. This is where al-Qaida maintains a virtual caliphate, a device that tricks thousands of impressionable young Muslims to espouse extremist doctrine. With the Internet now moving every 24 hours several million more words, documents and books than are contained in the entire Library of Congress, stumbling across terrorist intelligence in real time is as frequent as hitting multimillion-dollar jackpots in Las Vegas. This week, MEMRI's posts from the Jihad & Terrorism Threat Monitor between Sept. 1 and 10 consisted mostly of things extremists wanted publicized: -- Yaman Mukhaddab, a well-known author on jihadist forums, warns "al-Qaida's new trap has been laid" and predicts "days of calamity for the infidels." -- A Saudi al-Qaida defector says there is widespread dissatisfaction among al-Qaida operatives in AFPAK (Afghanistan-Pakistan) and that many want to desert. -- The "moderator" of the Al-Shura jihadist forum claims that an Osama bin Laden message has been "hijacked." -- A message from "Umm Hamza" from Lyon, France, asks al-Qaida Maghreb (North Africa) to save Muslim women from "Mad Dog" (President) Nicolas Sarkozy. -- Al-Shahab Al-Mujahideen reports successful operations in "Winds of Victory" offensive -- three of them in one day against the "Crusaders" and the "apostate militias" as part of its "Ramadan Winds of Victory offensive." Clearly, al-Qaida's terrorist operations these days have little to do with the war in Afghanistan. The Saudi Arabian Interior Ministry says security forces foiled 31 al-Qaida attacks on oil and other economic targets in the last five years. Last June, Mustafa Abu Al-Yazid, an al-Qaida commentator, said, "Hamas (in Gaza) and al-Qaida share the same ideology and the same doctrine." The AFPAK front also showed signs of division between the two wings of the Taliban. The Afghan Taliban organization declined a request for help from Taliban militants in Pakistan's Swat Valley by apparently reminding their Pakistani brothers of their policy of non-interference in Pakistan's internal affairs. The Afghan Taliban is under the overall command of Mullah Omar, the one-eyed underground leader who has not been seen since Sept. 11 but who maintains contact with Pakistan's Inter-Services Intelligence agency. The Pakistani Taliban was not defeated in the Swat Valley, as previously claimed. And the Pakistani army is reluctant to take on the Taliban in their tribal areas until the rest of the country is under control. In Sindh province, for example, the provincial government ordered special security arrangements for ministers, anti-Taliban religious scholars and key buildings following reports that 57 Taliban suicide bombers are planning simultaneous attacks. Over the past two years, suicide bombers have struck in every major city at least once and killed some 8,000 countrywide. Eight years after Sept. 11, the Taliban now has a permanent presence in 80 percent of Afghanistan, according to the International Council on Security and Development. And another 17 percent of the country is seeing "substantial" Taliban activity. In November 2007, ICOS assessed that the Taliban had a permanent presence in 54 percent of Afghanistan. A French political scientist, Sorbonne's Gilles Dorronsoro, with long experience in, and just back from, Afghanistan, told a Carnegie Foundation meeting in Washington that the much publicized joint operation by U.S. Marines and British troops in Helmand province had been a major disappointment. The ethnic map he produced showed the entire Pashtun belt, from the Iranian border to the Khyber Pass and north of the Kabul-Jalalabad highway, under Taliban control. Given the limitations on troop numbers for the U.S.-NATO coalition, Dorronsoro recommended that the countryside be left to the Taliban -- and U.S. airstrikes -- and that all available troops be assigned to the protection of the main cities. Failing such a redeployment of allied assets, several major cities could be hit simultaneously, as the Vietcong did in the Tet Offensive, Feb. 1, 1968, which convinced President Johnson and U.S. opinion that the war was unwinnable. Carnegie President Jessica Mathews says Dorronsoro has been "on target" for the last five years. The Vietcong strategy was not to take their 27 city objectives but to show they could enter them with impunity and cause much havoc and damage before pulling out. A similar offensive in Afghanistan could be successful with or without coalition troops protecting major cities. Taliban insurgents, looking like any other group of civilians at rush hour, could infiltrate and surround government buildings with concealed weapons. An Afghan Tet Offensive is a growing danger. Share This Article With Planet Earth
Related Links The Long War - Doctrine and Application
A new anthrax vaccine is under development
A new anthrax vaccine is under developmentNew York (UPI) Sep 9, 2009 Researchers in New York say they have identified two protein fragments that could be developed into a new anthrax vaccine. Scientists from Yeshiva University's Albert Einstein College of Medicine said their research suggests the protein fragments could lead to a vaccine with fewer side effects than the current vaccine. "Our research was motivated by the fact that the current ... read more |
|
| The content herein, unless otherwise known to be public domain, are Copyright 1995-2009 - SpaceDaily. AFP and UPI Wire Stories are copyright Agence France-Presse and United Press International. ESA Portal Reports are copyright European Space Agency. All NASA sourced material is public domain. Additional copyrights may apply in whole or part to other bona fide parties. Advertising does not imply endorsement,agreement or approval of any opinions, statements or information provided by SpaceDaily on any Web page published or hosted by SpaceDaily. Privacy Statement |